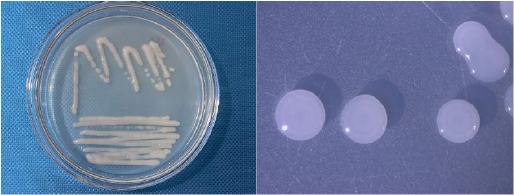

All published articles of this journal are available on ScienceDirect.
Isolation, Selection, and Biological Evaluation for Bacteria that Fix Nitrogen and Produce Indole-3-Acetic Acid from Paddy Soils in Vietnam
Abstract
Introduction/Background
Acidic soils are limiting the production of crops and indirectly harming the environment due to the use of nitrogen (N) chemical fertilizer. Therefore, the current study aims to isolate a promising N2-fixing candidate to solve this issue in some communes of Phu Luong District, Thai Nguyen Province, Vietnam.
Materials and Methods
The bacteria were isolated using the Ashby medium. The IAA generation and nitrogen fixation were assessed using spectroscopy. The selected bacteria were tested at temperatures ranging from 28°C to 42°C and pH levels of 4.0 to 9.0. As a result, the Box-Behnken model yielded a growth equation. The API kit test was used to measure the biochemical properties of the selected bacteria.
Results
The result demonstrated that there were ten nitrogen-fixing bacteria (NFB) isolates with capacities of N2 fixation and IAA production at 2.35–24.61 and 0.00–119.13 µg/ml. Among them, the NL3 strain was the best strain. The optimum condition to grow the NL3 strain was calculated as 5.44 days at pH 7.10 and temperature of 32.18°C to reach a bacterial density of 9.77929×108 CFU/ml. In addition, the NL3 strain was identified as an Azotobacter species. The genomic analysis revealed that the genome of Azotobacter sp. NL3 was nearly 5.4 Mb long and contained 45 N2 fixation-relating genes and 7 IAA production-relating genes.
Conclusion
Not only can this study provide insight into the features of Azotobacter spp., but it also introduces a potent candidate that can improve soil health and crop yield by fixing N2 and producing IAA in order to limit the use of N chemical fertilizer for a sustainable agriculture. Therefore, the selected bacterial strain should be further tested under the local field conditions and subsequently commercialized as a biofertilizer.
1. INTRODUCTION
Nitrogen (N) is a crucial nutrient for crops, influencing and limiting their growth and yield [1, 2]. It is generally used as N fertilizers in the form of CO(NH2)2 [2]. Moreover, the significant demand for food in response to overpopulation may lead to an increased utilization of nitrogen fertilizers [3]. However, the N fertilizer can be lost by up to 50% into the soil and environment [4, 5], also called nitrate pollution [1], which can ultimately harm human health [6, 7]. Therefore, the overuse of N fertilizers can lead to soil, underground water, and air contaminations [2, 5, 8, 9]. Many proposed approaches addressed this situation, such as using slow-release N fertilizer [3], combining N fertilizer with mulch [10], and applying N2-fixing bacteria (NFB) [11].
The pathway of N2 fixation is reducing free N2 in the atmosphere to ammonia under microaerobic conditions [1], which is facilitated by three types of nitrogenases (Mo-, V-, and Fe- nitrogenase) [1]. These enzymes are coded by nif genes [12, 13]. Some plants, especially the legume, which has been reported to intercrop with rice, maize, and wheat, have been reported to be able to fix N2 by having a symbiotic relationship with NFB either in the soil or inside the root itself [1, 5, 14]. One well-known NFB is Astragalus sinicus [12]. Singh et al. [2] reported that many N2-fixing bacteria proved their abilities to act as a biocontrol and promote plant growth in sugarcane, such as Bacillus megaterium and Bacillus mycoides. Among these bacteria, Azotobacter spp. is a well-known candidate [5]. Moreover, these bacteria species can induce plant resistance to environmental stresses and produce plant growth-producing substances (PGPS), such as indole-acetic acid (IAA), gibberellins, and cytokinin [5]. Therefore, Azotobacter spp. has been developed as a biofertilizer [15]. Furthermore, bacterial IAA is such a popular PGPS that it can be used to evaluate the plant growth-promoting potential of a bacterium [16].
In Thai Nguyen Vietnam, the soil is classified as Kanhaplustult ultisoils [17, 18], with a low pH and a high concentration of nutrients, including N. Moreover, acidic soils can lead to great toxicities of Al, Fe, and Mn and low availability of N, phosphorus (P), Ca, potassium (K), and Mg [19, 20]. A study conducted in Thai Nguyen, Vietnam, found that prolonged nitrogen fertilization resulted in a modest rise in the soil's overall N content. However, it also decreased the levels of P and K [21], while the nutrient availability could be a constraint of crop growth and yield [4]. Given such difficulties in Thai Nguyen, Vietnam, finding an indigenous NFB strain to improve soil health and crop production is an ideal solution for sustainable agriculture here. Therefore, the study was conducted to isolate strong NFB strains in Thai Nguyen soils in order to evaluate their IAA production along with their morphological and biochemical characteristics.
2. MATERIALS AND METHODS
2.1. Isolation of N2-fixing and IAA-producing Bacteria
Bacteria strains were collected from soils in communes of Luong Phu, Tuc Tranh, Vo Tranh, and Phan Me of Phu Luong District, Thai Nguyen Province, Vietnam.
The isolation was conducted on an Ashby medium containing 20.0 g Mannitol, 0.2 g K2HPO4, 0.2 g MgSO4, 0.2 g NaCl, 0.1g K2SO4, and 5.0 g CaCO3 in a litter of solution made up of distilled water. Bacteria strains that can live and propagate in the Ashby medium were able to fix N2.
The N2-fixing bacterial strains were cultured in an Ashby medium supplied with L-tryptophan 0.1%. Strains that can change the color of the Salkowski indicator were able to produce IAA, according to the method of Glikmann and Dessaux (1995).
2.2. Selection for N2-fixing and IAA-producing Bacteria
The quantification of IAA production was based on the standard IAA solution reacting with the Salkowski indicator and measured for a certain ultraviolet (UV) absorbance. The bacteria were cultured in Ashby broth (supplemented with tryptophan 0.1%) at 30°C and shaken at 150 rpm for seven days.Subsequently, the culture was mixed with the Salkowski indicator and measured for UV absorbance.
The N2-fixing capacity was based on the production of NH4+ in the bacterial culture. The bacterial strains were continuously cultured in Ashby broth at 30°C and shaken at 150 rpm for seven days. The culture was then mixed with the Nessler indicator and measured for UV absorbance.
2.3. Biological Evaluation for N2-fixing and IAA-producing Bacteria
Bacteria colonies were observed under a Scanning Electron Microscope (SEM) at a focal distance of 5 µm for morphology.
The effects of temperature and pH on the growth of the isolated strains were also assessed. The temperatures used were 28°C, 30°C, 32°C, 34°C, 36°C, 38°C, 40°C, and 42°C, while the variations of pH were 4.0, 4.5, 5.0, 5.5, 6.0, 6.5, 7.0, 7.5, 8.0, 8.5, and 9.0. The pH was adjusted by the following buffer solution: Na2HPO4 and KH2PO4. The culture was conducted based on the above temperature or pH variation for five days. The cell density was measured according to an optical density (OD) at 610 nm. Hence, an optimal condition was established according to the Box-Behnken model with 17 experimental units and three replications. The optimized factors consisted of the following: culture duration (X1) with -1, 0, and +1 corresponding to 4, 5, and 6 days; culture temperature (X2) with -1, 0, and +1 corresponding to 30°C, 32°C, and 34°C; and culture pH (X3) with -1, 0, and +1 corresponding to 6.5, 7, and 7.5. From there, a multivariate model showing the cell density was established using the regression analysis. Analysis of variance (ANOVA) was applied to evaluate the established model and the interactions between factors affecting cell density. The expectation function method was used to optimize the density of NL3 cells obtained from the culture process using the Design-Expert software (DX 7.1.5).
The production of some enzymes, including phosphatase alkaline, esterase (C4), esterase lipase (C8), lipase (C14), leucine arylamidase, valine arylamidase, cystine arylamidase, trypsin, D-chymotrypsin, acid phosphatase, naphthol-AS-BI-phosphohydrolase, D-galactosidase, ß-galactosidase, ß-glucuronidase, D-glucosidase, ß-glucosidase, N-acetyl-ß-glucosaminidase, D-mannosidase, and D-fucosidase, was tested using the API ZYM kit. The biochemical functions of the bacteria were evaluated using the API kit.
3. RESULTS AND DISCUSSION
3.1. Isolation for N2-fixing and IAA-producing Bacteria
In Table 1, 10 strains can live in Ashby, which is labeled as NL3, NL21. NL22, NL23, NL24, NL213, NL215, NL226, NL235, and NL247. Moreover, their origin of isolation is shown in Table 1. Among them, seven strains can synthesize IAA.
Their N2-fixing and IAA-producing capacities have been evaluated and shown in Table 2. The amount of NH4+ produced by the bacteria fluctuated from 24.61 µg/ml, while the IAA production was recorded as 11.33-119.13 µg/ml. Among them, the most significant amount of NH4+ and IAA belonged to the NL3 strains. Therefore, this strain was chosen for the following experiment. This is in accordance with previous studies, where some NFB strains can produce IAA [16, 22-24]. For example, in the study by Fang et al. [22], 131 strains were isolated from the roots of Ageratina adenophora. They can perform both N2 fixation and IAA production, leading to significant improvement in plant growth as well. However, the IAA and N2 fixation vary between various studies in different locations. Some NFB strains in South Sulawesi, Indonesia, showed IAA-producing results from approximately 300 to nearly 1,800 µg/ml [23]. Concurrently, in the study by Wagi and Ahmed [16], two Bacillus spp. can produce IAA of roughly 35.8–36.6 µg/ml. A Curtobacterium sp. strain in China can fix N2 up to 13.38 µg/ml [24]. However, these above strains were proven to be capable of conducting other plant growth-promoting activities [25], such as P solubilization [22] and siderophores production [16]. Unfortunately, these characteristics were not investigated in our study. Therefore, they should be tested in future studies in which a field trial should be taken with a cultivar habiting in Thai Nguyen Province, Vietnam, such as tea [17], to assess the effects of the selected bacteria on soil health and plant productivity.
| Strain | Location of Isolation | N2-fixing Ability | IAA-producing Ability |
|---|---|---|---|
| NL3 | Luong Phu commune | + | + |
| NL21 | Luong Phu commune | + | + |
| NL22 | Tuc Tranh commune | + | + |
| NL23 | Tuc Tranh commune | + | + |
| NL24 | Vo Tranh commune | + | + |
| NL213 | Vo Tranh commune | + | - |
| NL215 | Vo Tranh commune | + | - |
| NL226 | Phan Me commune | + | - |
| NL235 | Phan Me commune | + | + |
| NL247 | Phan Me commune | + | + |
| No. | Strain | IAA-producing Capacity (µg/ml) | N2-fixing Capacity (µg/ml) |
|---|---|---|---|
| 1 | NL3 | 119.13 | 24.61 |
| 2 | NL21 | 30.68 | 12.15 |
| 3 | NL22 | 11.33 | 7.43 |
| 4 | NL23 | 29.16 | 5.25 |
| 5 | NL24 | 70.91 | 14.64 |
| 6 | NL213 | - | 11.56 |
| 7 | NL215 | - | 6.23 |
| 8 | NL226 | - | 2.35 |
| 9 | NL235 | 11.39 | 4.78 |
| 10 | NL247 | 7.66 | 3.24 |
Table 3.
| No. | Strain | Colony Morphology | Cell Morphology | Gram | Motility |
|---|---|---|---|---|---|
| 1 | NL3 | Round, translucent white to greenish white, convex, compact, glistened, and slimy | Short rod | - | + |
| 2 | NL21 | Round, opaque white, convex, smooth, glistened, and slimy | Oval - round | - | + |
| 3 | NL22 | Round, opaque white, wrinkled, crateriform, and rough surface | Oval - round | - | + |
| 4 | NL23 | Opaque white, round with nucleus, smooth, convex, nonfilamentous | Oval | - | + |
| 5 | NL24 | Round, translucent white, glistened, nonfilamentous, slimy, and raised | Short rod | - | + |
| 6 | NL213 | Round, opaque white, glistened surface, nonfilamentous, slimy, and raised | Coma | - | + |
| 7 | NL215 | Round, translucent white, glistened surface, filiform, and slimy | Short rod | - | + |
| 8 | NL226 | Opaque white, round and without filament, rough surface | Oval | - | + |
| 9 | NL235 | Translucent white, irregular, filiform, flat, and rough surface | Short rod | - | + |
| 10 | NL247 | Opaque white, round, convex, filiform, lobate, and rough | Short rod | - | + |
Additionally, the cell and colony features of the isolated bacterial strains are also listed in Table 3. Although they were all generally white, Gram-negative, and mobile, their cell and colony morphological traits varied. In particular, the NL3 strain had short rod-shaped cells and colonies that were round, translucent white to greenish white, convex, compact, glistened, and slimy (Figs. 1 and 2). This is in accordance with the study by Tang et al. [26] and Mahmud et al. [1], where the NFB were also commonly Gram-negative with convex colonies, especially the Azotobacter spp [27]. with motility [28].
3.2. Growth Evaluation for the NL3 Strain
The bacterial density of the NL3 strain ranged from 0.007 to 9.337 x 108 CFU/ml from 28°C to 42°C. The result peaked at 32°C and bottomed at 42°C (Table 4). Conversely, the bacterial density fluctuated from 0.007 to 9.337 x 108 CFU/ml under pH from 4.5 to 9.0. The greatest result was found in the pH 7.0, whereas the lowest one was in the pH 4.5 (Table 5). This is in accordance with the study by Mukhtar et al. [29], where it was reported that the Azotobacter spp. have survivable conditions of pH 5–9 and temperature of 25–40°C.
Based on the Box-Behnken practical matrix of culture duration (X1), temperature (X2), and pH (X3), the function showing the bacterial density of the NL3 strain was formulated as follows: Y = + 9.1 + 1.69*X1 + 0.066*X2 + 1.8*X3 + 0.37*X1*X2 + 1.45*X1*X3 – 0.47*X2*X3 – 2.08*X12 – 2.33*X22 – 3.66*X32. The matrix is shown in Table 6. As observed, all the factors affected the bacterial density of the Azotobacter sp. NL3 strain. However, when combined with each other or the factors above the limit, the influences could be negative.

| No. | Strain | Bacterial Density (x 108 CFU/ml) After Five Days of Culture at a Certain Temperature | |||||||
|---|---|---|---|---|---|---|---|---|---|
| 28oC | 30oC | 32oC | 34oC | 36oC | 38oC | 40oC | 42oC | ||
| 1 | NL3 | 9.067 | 9.307 | 9.337 | 8.087 | 6.127 | 1.197 | 0.507 | 0.007 |
| Strain | Bacterial Density (x 108 CFU/ml) After Five Days of Culture at a Certain pH | |||||
|---|---|---|---|---|---|---|
| pH = 4.0 | pH = 4.5 | pH = 5.0 | pH = 5.5 | pH = 6.0 | pH = 6.5 | |
| NL3 | - | 0.007 | 0.757 | 2.087 | 8.957 | 9.297 |
| Strain | Bacterial density (x 108 CFU/ml) after five days of culture at a certain pH | |||||
| pH = 7.0 | pH = 7.5 | pH = 8.0 | pH = 8.5 | pH = 9.0 | ||
| NL3 | 9.337 | 9.197 | 7.117 | 1.617 | 0.097 | |
| Experiment | Variables | NL3 Density (108CFU/ml) | ||
|---|---|---|---|---|
| X1 Culture Duration (days) | X2 Culture Temperature (°C) | X3 Culture pH | ||
| 1 | 4.00 | 30.00 | 7.00 | 3.2251 |
| 2 | 6.00 | 30.00 | 7.00 | 5.654 |
| 3 | 4.00 | 34.00 | 7.00 | 2.9862 |
| 4 | 6.00 | 34.00 | 7.00 | 6.8982 |
| 5 | 4.00 | 32.00 | 6.50 | 1.294 |
| 6 | 6.00 | 32.00 | 6.50 | 1.9709 |
| 7 | 4.00 | 32.00 | 7.50 | 1.8614 |
| 8 | 6.00 | 32.00 | 7.50 | 8.3416 |
| 9 | 5.00 | 30.00 | 6.50 | 0.8959 |
| 10 | 5.00 | 34.00 | 6.50 | 1.6026 |
| 11 | 5.00 | 30.00 | 7.50 | 5.5644 |
| 12 | 5.00 | 34.00 | 7.50 | 4.3798 |
| 13 | 5.00 | 32.00 | 7.00 | 9.1081 |
| 14 | 5.00 | 32.00 | 7.00 | 9.337 |
| 15 | 5.00 | 32.00 | 7.00 | 9.2375 |
| 16 | 5.00 | 32.00 | 7.00 | 8.9787 |
| 17 | 5.00 | 32.00 | 7.00 | 8.8592 |
| Source | Standard F | P values |
|---|---|---|
| Model | 240.60 | <0.0001 |
| Lack of Fit | 3.52 | 0.1276 |
| R2 | 0.9968 | |
Table 7 demonstrates the significance and compatibility of the formulated model. The significance value of the model was P value < 0.0001 < 0.05. Therefore, the model was selected with a regressive coefficient of R2 = 0.9968, showing that the practical data were compatible with the predicted model.
On the other hand, the expectation function method optimized the bacterial density of the NL3 strain. In total, 43 options were found, and the best one for the maximum NL3 density function was 5.44 days of culture at 32.18°C and pH = 7.10 (Fig. 3), at which the maximum bacterial density was 9.77929 x 108 CFU/ mL (Fig. 4). However, the optimum growth observed in the study by Mukhtar et al. [29] was at pH 8 and 30°C. This could be the different species or the different location of origin. In Thai Nguyen, the temperature is moderately high, and the soil is acidic [17, 30], leading to a lower optimum pH and higher optimum temperature of Azotobacter sp. in this study.


Note: (a) The interactive model between culture duration and temperature; (b) the interactive model between culture duration and pH; (c) the interactive model between culture temperature and pH.
3.3. Biochemical Function of the NL3 Strain
The NL3 showed a positive trait of producing alkaline phosphatase, esterase, lipase, leucine arylamidase, valine arylamidase, phosphatase acid, naphthol-AS-BI-phospho- hydrolase, and D-glucosidase (Table 8). Moreover, the NL3 strain was proven to be able to produce indole, catalase, and oxidase to assimilate esculin ferric citrate, D-glucose, D-mannitol, potassium gluconate, capric acid, malic acid, trisodium citrate, L-rhamnose, inositol, D-saccharose, lactic acid, glycogen, D-melibiose, D-sorbitol, valeric acid, potassium 2-ketogluconate, 3-hydroxybutyric acid, 4-hydroxybenzoic acid, and D-fructose and perform red methyl reaction, Voges–Proskauer reaction, and H2S production (Table 9). In the current study, the bacterial strain NL3 can perform glucose fermentation, H2O2 naturalization, citrate and indole utilization, and urease production [28].
3.4. Genomic Study of the NL3 Strain
The result of the before and after purification is described in Table 10. The total number of sequences before and after purification showed that the Illumina sequencing score had a Q30 rate above 80%, which is qualified for the de novo assembly [31].
The assembly result is displayed in Table 11, which illustrates that the total length of contigs was 5,378,928 bp and suitable for the NL3’s genome size (roughly 5 Mb). The longest contig was 5,378,928 bp long, accounting for 100% of the total contig length. This is consistent with the study by Setubal et al. [32], where the length of an Azotobacter sp. was roughly 5.4 Mb.
| No. | Enzyme Production | NL3 |
|---|---|---|
| 1 | Control | - |
| 2 | Alkaline phosphatase | + |
| 3 | Esterase (C4) | + |
| 4 | Esterase Lipase (C8) | - |
| 5 | Lipase (C14) | + |
| 6 | Leucine arylamidase | + |
| 7 | Valine arylamidase | + |
| 8 | Cystine arylamidase | - |
| 9 | Trypsin | - |
| 10 | D-chymotrypsin | - |
| 11 | Acid phosphatase | + |
| 12 | Naphthol-AS-BI-phosphohydrolase | + |
| 13 | D-galactosidase | + |
| 14 | ß-galactosidase | - |
| 15 | ß-glucuronidase | - |
| 16 | D-glucosidase | + |
| 17 | ß-glucosidase | - |
| 18 | N-acetyl-ß-glucosaminidase | - |
| 19 | D-mannosidase | - |
| 20 | D-fucosidase | - |
| No. | Biochemical Index | Activity |
|---|---|---|
| 1 | Convert nitrate to nitrite | - |
| 2 | Produce indole | + |
| 3 | Ferment D-glucose | - |
| 4 | Assimilate L-arginine | - |
| 5 | Assimilate urea | - |
| 6 | Assimilate esculin ferric citrate | + |
| 7 | Assimilate gelatin | - |
| 8 | Assimilate 4-nitrophenyl-β D-glucopyranoside | - |
| 9 | Assimilate D-glucose | + |
| 10 | Assimilate L-arabinose | - |
| 11 | Assimilate D-mannose | - |
| 12 | Assimilate D-mannitol | + |
| 13 | Assimilate N-acetyl-glucosamine | - |
| 14 | Assimilate D-maltose | - |
| 15 | Assimilate potassium gluconate | + |
| 16 | Assimilate capric acid | + |
| 17 | Assimilate adipic acid | - |
| 18 | Assimilate malic acid | + |
| 19 | Assimilate trisodium citrate | + |
| 20 | Assimilate phenylacetic acid | - |
| 21 | Assimilate L-rhamnose | + |
| 22 | Assimilate D-ribose | - |
| 23 | Assimilate inositol | + |
| 24 | Assimilate D-saccharose | + |
| 25 | Assimilate Itaconic acid | - |
| 26 | Assimilate suberic acid | - |
| 27 | Assimilate sodium malonate | - |
| 28 | Assimilate sodium acetate | - |
| 29 | Assimilate lactic acid | + |
| 30 | Assimilate L-alanine | - |
| 31 | Assimilate potassium 5-ketogluconate | - |
| 32 | Assimilate glycogen | + |
| 33 | Assimilate 3-hydroxybenzoic acid | - |
| 34 | Assimilate L-serine | - |
| 35 | Assimilate salicin | - |
| 36 | Assimilate D-melibiose | + |
| 37 | Assimilate L-fucose | - |
| 38 | Assimilate D-sorbitol | + |
| 39 | Assimilate propionic acid | - |
| 40 | Assimilate valeric acid | + |
| 41 | Assimilate L-histidine | - |
| 42 | Assimilate potassium 2-ketogluconate | + |
| 43 | Assimilate 3-hydroxybutyric acid | + |
| 44 | Assimilate 4-hydroxybenzoic acid | + |
| 45 | Assimilate L-proline | - |
| 46 | Assimilate D-xylose | - |
| 47 | Assimilate D-fructose | + |
| 48 | Assimilate lactose | - |
| 49 | Catalase activity | + |
| 50 | Oxidase activity | + |
| 51 | Red methyl reaction | + |
| 52 | Voges–Proskauer reaction | + |
| 53 | Produce H2S | + |
| Sample | The Number of Read |
Base Total (bp) |
Length (bp) |
%GC | % Q30 |
|---|---|---|---|---|---|
| Before purification | |||||
| Forward sequencing R1 | 1,953,179 | 294,930,029 | 35-151 | 64.8 | 95.0 |
| Reverse sequencing R2 | 1,953,179 | 294,930,029 | 35-151 | 64.8 | 94.3 |
| After purification | |||||
| Forward sequencing R1 | 1,870,981 | 282,416,622 | 35-151 | 64.7 | 96.2 |
| Reverse sequencing R2 | 1,870,981 | 282,416,622 | 35-151 | 64.8 | 95.6 |
| Genomic Characteristics | Quantity |
|---|---|
| The number of contigs | 1 |
| The number of circles contigs | 1 |
| %GC (contigs >500 bp) | 65.65 |
| Total length of contigs (bp) | 5,378,928 |
| The longest contig length (bp) | 5,378,928 |
| N50 value (contigs >500 bp) | 5,378,928 |
| L50 value (contigs >500 bp) | 1 |
| CDS | 5321 |
| tRNA | 64 |
| rRNA | 18 |
| The number of protein functional coding genes: | - |
| Hypothesis protein | 1233 |
| Functional protein | 4088 |
| Protein with EC indicator | 1232 |
| Protein with GO arrangement | 1059 |
| Signaling proteins | 935 |
| Systematic protein | 1710 |
| Protein for PLfam, especially for the PATRIC genus | 5200 |
| Protein with the family-genus mission of PATRIC (PGfam) | 5205 |
| Protein with FIGfam mission | 0 |

| No. | Function/Pathway |
|---|---|
| Genes relating to N2 fixation: | |
| 1 | Nitrogenase (molybdenum-iron)-specific transcriptional regulator NifA |
| 2 | Nitrogenase (iron-iron) transcriptional regulator |
| 3 | Nitrogenase-associated protein NifO |
| 4 | Nitrogenase (iron-iron) transcriptional regulator |
| 5 | AnfO protein, required for Mo- and V-independent nitrogenase |
| 6 | AnfR protein, required for Mo- and V-independent nitrogenase |
| 7 | Nitrogenase (iron-iron) beta chain (EC 1.18.6.1) |
| 8 | Nitrogenase (iron-iron) alpha chain (EC 1.18.6.1) |
| 9 | Nitrogenase (iron-iron) delta chain (EC 1.18.6.1) |
| 10 | Nitrogenase (iron-iron) reductase and maturation protein AnfH |
| 11 | Nitrogenase (iron-iron) transcriptional regulator |
| 12 | Nitrogenase (molybdenum-iron)-specific transcriptional regulator NifA |
| 13 | 4Fe-4S ferredoxin, nitrogenase-associated |
| 14 | Nitrogenase FeMo-cofactor synthesis FeS core scaffold and assembly protein NifB |
| 15 | Nitrogenase-associated protein NifO |
| 16 | Nitrogenase FeMo-cofactor synthesis molybdenum delivery protein NifQ |
| 17 | Nitrogenase (molybdenum-iron) reductase and maturation protein NifH |
| 18 | Nitrogenase (molybdenum-iron) alpha chain (EC 1.18.6.1) |
| 19 | Nitrogenase (molybdenum-iron) beta chain (EC 1.18.6.1) |
| 20 | NifT protein |
| 21 | Nitrogenase FeMo-cofactor scaffold and assembly protein NifE |
| 22 | LRV (FeS)4 cluster domain protein clustered with nitrogenase cofactor synthesis |
| 23 | Nitrogenase FeMo-cofactor scaffold and assembly protein NifN |
| 24 | Nitrogenase FeMo-cofactor carrier protein NifX |
| 25 | NifX-associated protein |
| 26 | Uncharacterized protein RPC_4456 |
| 27 | Iron-sulfur cluster assembly scaffold protein NifU |
| 28 | Probable iron-binding protein from the HesB_IscA_SufA family in Nif operon |
| 29 | Cysteine desulfurase (EC 2.8.1.7) => NifS |
| 30 | Nitrogenase stabilizing/protective protein NifW |
| 31 | Nitrogenase vanadium-cofactor synthesis protein VnfY |
| 32 | NifZ protein |
| 33 | Homocitrate synthase (EC 2.3.3.14) |
| 34 | Nitrogenase (vanadium-iron) beta chain (EC 1.18.6.1) |
| 35 | Nitrogenase (molybdenum-iron) reductase and maturation protein NifH |
| 36 | Nitrogenase (vanadium-iron) alpha chain (EC 1.18.6.1) |
| 37 | Nitrogenase vanadium-cofactor synthesis protein VnfX |
| 38 | Nitrogenase (vanadium-iron) delta chain (EC 1.18.6.1) |
| 39 | 4Fe-4S ferredoxin, nitrogenase-associated |
| 40 | Nitrogenase vanadium-cofactor synthesis protein VnfN |
| 41 | Nitrogenase vanadium-cofactor synthesis protein VnfE |
| 42 | Electron transfer flavoprotein, beta subunit FixA |
| 43 | Electron transfer flavoprotein, alpha subunit FixB |
| 44 | Electron transfer flavoprotein-quinone oxidoreductase FixC |
| 45 | Ferredoxin-like protein FixX |
| Gens relating to IAA production: | |
| 1 | Indole-3-acetate_biosynthesis_I |
| 2 | Indole-3-acetate_biosynthesis_III |
| 3 | Indole-3-acetate_biosynthesis_IV |
| 4 | Indole-3-acetate_biosynthesis_V |
| 5 | L-tryptophan_degradation_VII |
| 6 | L-tryptophan_degradation_X |
| 7 | Methyl_indole-3-acetate_interconversion |

The genomic map of the NL3 strain is built in Fig. (5). The analysis results show that from the center outward, circle 1 illustrates the tilt of the GC. Circle 2 showed the GC content (peaks outside or inside of the circle indicate values that were higher or lower than the average G+C content, respectively). Circle 3 represents the ncRNA gene. Circles 4, 5, and 6 represent CDS, with colors according to the COG, KEGG, and GO categories, respectively. Circle 7 represents the functionally predicted protein-coding sequences.
According to Fig. (6), the NL3 strain was identified as an Azotobacter sp. with an accession number of OR125577, which was closely related to the Azotobacter vinelandii IAM 15004T strain.
3.5. Primary Analysis of Genetic Structures for N2 Fixation and IAA Production of the Azotobacter sp. NL3
Based on the genome of the NL3 strain, 45 genes were found relating to N2 fixation by the NL3 strain. The result is presented in Table 12 and Fig. (7) with nif and fix genes that directly participated in N2-fixation. Furthermore, genomic analysis of the NL3 strain also provided 07 genes participating in IAA metabolism and referred in the MetaCyc database (Table 12 and Fig. 8).


CONCLUSION
From acidic soils in some communes of Thai Nguyen province, Vietnam, ten isolates of NFB were found. Among them, the NL3 strain performed the greatest N2 fixation and IAA production (roughly 24.61 and 119.13 µg/ml, respectively). The optimum pH and temperature were correspondingly 7.10 and 32.18°C for the maximum bacterial density of 9.77929x108 CFU/ml according to the Box-Behnken-based growth function as follows: Y = + 9.1 + 1.69*X1 + 0.066*X2 + 1.8*X3 + 0.37*X1*X2 + 1.45*X1*X3 – 0.47*X2*X3 – 2.08*X12 – 2.33*X22 – 3.66*X32. Furthermore, the NL3 strain was identified as an Azotobacter sp. with a nearly 5.4 Mb long genome containing 45 N2-fixing genes and 7 IAA-producing genes. The newly isolated Azotobacter sp. is promising to improve soil fertility and crop productivity and reduce the use of chemical fertilizer on acidic soil for sustainable agriculture. However, the study did not measure the plant growth promotion and soil remediation by the selected bacteria. We will conduct those in the future study. Nevertheless, there are difficulties in selecting appropriate carriers for bacteria to survive under field conditions, determining reasonable costs for farmers’ use, and raising farmers’ awareness of the importance of using biofertilizers rather than chemical fertilizers.
LIST OF ABBREVIATIONS
| OD | = Optical Density |
| SEM | = Scanning Electron Microscope |
| NFB | = Nitrogen-fixing Bacteria |
AVAILABILITY OF DATA AND MATERIALS
The data that support the findings of this study are available from the corresponding author, [H.A], on special request.

